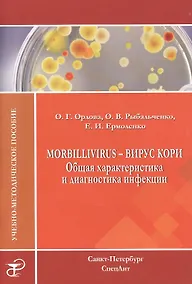
Купить Morbillivirus - вирус кори. Общая характеристика и диагностика инфекции: учебно-методическое пособие — Фото №1

Хинцман Йорн: УЗИ опорно-двигательного аппарата: стандартные плоскости сканирования/ 2-е изд.
Купили 21 раз
О товаре
Технический прогресс сегодня позволяет получить с помощью УЗИ детальное изображение анатомических структур, при этом заметно дешевле и проще компьютерной и магнитно-резонансной томографии, что вызывает повышенный интерес к данному методу исследования.
Это оригинальное руководство оценят все специалисты, имеющие отношение к УЗИ опорно-двигательного аппарата. Авторы обобщили все современные данные и представили их в наглядном виде. Для каждой плоскости сканирования представлены показания, техника, цель исследования; представлены УЗ-изображение и его схема. Детально описаны положения пациента и исследуемой части тела, а также самого врача, что проиллюстрировано фотоснимками. Особое внимание уделено точному нащупыванию поверхностных анатомических ориентиров, что облегчает исследование в стандартной плоскости.
Руководство позволяет обобщить и углубить знания в области УЗИ, может быть использовано в качестве краткого атласа и будет ценным подспорьем для практикующих ортопедов, хирургов, травматологов, а также всех специалистов в области УЗИ опорно-двигательного аппарата.
Характеристики
- Автор:
- Йорн Хинцман
- Раздел:
- Медицина и здоровье
- Издательство:
- МЕДпресс-информ
- ISBN:
- Год издания:
- 2014
- Количество страниц:
- 144
- Переплет:
- Мягкий переплёт
- Формат:
- 140x210 мм
- Вес:
- 0.26 кг
Похожие товары
Отзывов ещё нет — вы можете быть первым.